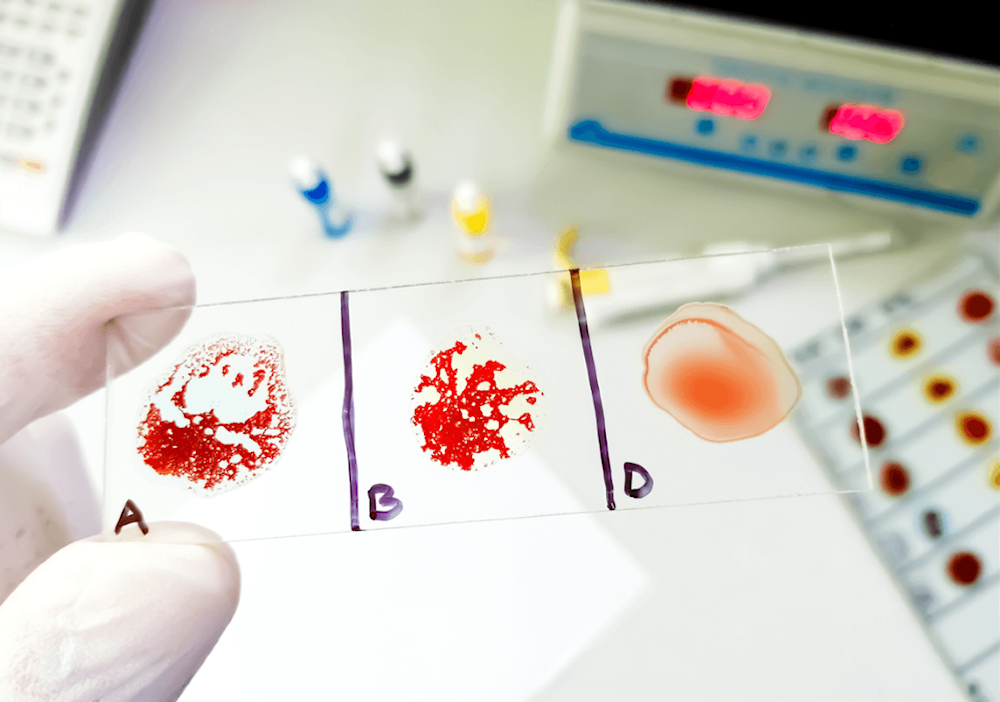

علماء روس يحددون زمن صلاحية الدم لإجراء الاختبار عليه
عينات الدم المأخوذة لفحصها وإجراء اختبارات عليها تخضع صلاحيتها لفتزة زمنية محدودة جداً. علماء روس يحددون زمن هذه الصلاحية.. إليكم التفاصيل.
-
تجارب الدم تحت المجهر: عدد الساعات الحاسمة قبل فساد العينة هو أربع ساعات فقط
نصح علماء روس من جامعة البلطيق الفيدرالية الروسية (BFU) أنّ الوقت الأمثل لإجراء التجارب على الصفائح الدموية البشرية يتراوح بين ساعتين إلى أربع ساعات فقط، وذلك بعد دراسة حالة الصفائح باستخدام تقنية التحليل الطيفي للانتشار الراماني.
وأكّد العلماء أنّ الصفائح الدموية هي خلايا دم تلعب دوراً رئيسياً في وقف النزيف، حيث تشكل جلطات على المناطق المتضررة من الأوعية الدموية، ويزيد الإفراط فيها من خطر تشكل الجلطات، ما يؤدي إلى احتشاء عضلة القلب أو السكتة الدماغية، بينما يؤدي نقصها إلى النزيف.
وأوضحوا أنّ التحليل الطيفي للانتشار الراماني يتيح الحصول على معلومات حول التركيب الكيميائي الحيوي للصفائح الدموية، واكتشاف التغييرات الهيكلية المبكرة في الخلايا.
ما هو الدم؟
المعروف أنّ الدم هو نسيج سائل يشكل نحو 7-8% من وزن الجسم، ويضخه القلب ليصل إلى كل زاوية وركن في أجسادنا. يمكن تشبيهه بنظام النقل المتكامل في مدينة مزدحمة؛ فهو الشرايين والأوردة التي تنقل كل ما هو ضروري للحياة.
مهمة الدم الأساسية هي نقل الأكسجين من الرئتين إلى الخلايا، ونقل المواد الغذائية من الجهاز الهضمي. وفي رحلة العودة، يجمع ثاني أكسيد الكربون والفضلات ليتم التخلص منها. من دون هذا النظام الفعال، تتوقف الحياة.
من جهتها، قالت إليزافيتا ديميشكيفيتش، الباحثة في مركز البحث العلمي "الفوتونيات الأساسية والتطبيقية، الفوتونيات النانوية" في جامعة "إيمانويل كانط" البلطيقية الفيدرالية (BFU)" إنّ العديد من العلماء يستخدمون حالياً هذه الطريقة البصرية لدراسة أمراض القلب والأوعية الدموية.
وأشارت إلى أنّ "هذه الطريقة شائعة جداً وواعدة"، وأنّ "العلماء يجرون عليها تعديلات مستمرة، إلا أنها تتضمن دائماً العمل مع السوائل البيولوجية، وخاصةً الصفائح الدموية في البلازما الغنية بالصفائح الدموية".
وشددت ديميشكيفيتش على أنه "للحصول على نتائج موثوقة عند العمل مع هذه الخلايا المعقدة التي تستجيب لعوامل بيئية مختلفة، من الضروري الحفاظ على بنيتها الجزيئية الأصلية بعناية".
وتابعت: "لقد أثبتنا أنّ الوقت الأمثل لإجراء التجارب على الصفائح الدموية والحصول على نتائج موثوقة هو من ساعتين إلى أربع ساعات عند تخزين خلايا الدم عند درجة حرارة 4 درجات مئوية"، مشددةً على أنه بعد هذا الوقت، "تتدهور" الصفائح الدموية، حيث تبدأ بالخضوع لبعض التغييرات الهيكلية.
وأكّد العلماء الروس أنّ النتائج التي تمّ الحصول عليها يمكن أن تكون مفيدة للمؤسسات التي تستخدم البلازما الغنية بالصفائح الدموية، مثل المختبرات التجارية وعيادات التجميل، حيث يزداد رواج علاج شد الوجه بالبلازما (PRP)، ويتضمن هذا الإجراء حقن بلازما المريض نفسه لتنشيط عمليات تجديد البشرة وتجديدها.














